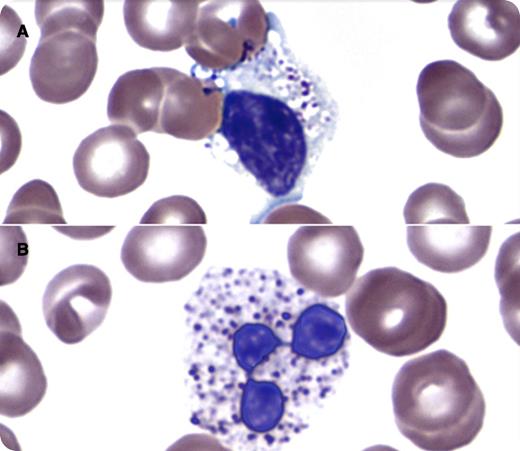
A 35-year-old woman with a history of systemic lupus erythematosus presented with 3 weeks of cough and nasal congestion. She was presumed to have an upper respiratory tract infection. Blood counts showed leukopenia (white blood cell count, 1.8 × 109/L) with absolute neutropenia (0.25 × 109/L). A peripheral blood smear showed granulocytes and lymphocytes with cytoplasmic vacuoles of variable size. Within some vacuoles were dense, basophilic, round to ovoid granules (panel A, lymphocyte; panel B, neutrophil). Review of prior laboratory data reported abnormal granulation within lymphocytes and granulocytes for ∼14 months. Evaluation of the patient’s medication history revealed that she was started on chloroquine therapy ∼16 months prior. Follow-up identified no specific infectious etiology for the patient’s symptoms and the neutropenia resolved without intervention. / Morphologic changes have been described in leukocytes in patients undergoing chloroquine therapy. Changes seen may include an increase in cytoplasmic vacuoles, some containing irregular inclusions. One theoretical mechanism to explain this phenomenon includes an inhibitory effect of chloroquine on enzymes involved in degradation of lysosomal constituents. Such morphologic changes should be distinguished from intracellular organisms and signs of leukocyte activation (neutrophil toxic granulation, large granular lymphocytes). Careful review of clinical data and medication history may facilitate recognition of this phenomenon.

A 35-year-old woman with a history of systemic lupus erythematosus presented with 3 weeks of cough and nasal congestion. She was presumed to have an upper respiratory tract infection. Blood counts showed leukopenia (white blood cell count, 1.8 × 109/L) with absolute neutropenia (0.25 × 109/L). A peripheral blood smear showed granulocytes and lymphocytes with cytoplasmic vacuoles of variable size. Within some vacuoles were dense, basophilic, round to ovoid granules (panel A, lymphocyte; panel B, neutrophil). Review of prior laboratory data reported abnormal granulation within lymphocytes and granulocytes for ∼14 months. Evaluation of the patient’s medication history revealed that she was started on chloroquine therapy ∼16 months prior. Follow-up identified no specific infectious etiology for the patient’s symptoms and the neutropenia resolved without intervention.
Morphologic changes have been described in leukocytes in patients undergoing chloroquine therapy. Changes seen may include an increase in cytoplasmic vacuoles, some containing irregular inclusions. One theoretical mechanism to explain this phenomenon includes an inhibitory effect of chloroquine on enzymes involved in degradation of lysosomal constituents. Such morphologic changes should be distinguished from intracellular organisms and signs of leukocyte activation (neutrophil toxic granulation, large granular lymphocytes). Careful review of clinical data and medication history may facilitate recognition of this phenomenon.
A 35-year-old woman with a history of systemic lupus erythematosus presented with 3 weeks of cough and nasal congestion. She was presumed to have an upper respiratory tract infection. Blood counts showed leukopenia (white blood cell count, 1.8 × 109/L) with absolute neutropenia (0.25 × 109/L). A peripheral blood smear showed granulocytes and lymphocytes with cytoplasmic vacuoles of variable size. Within some vacuoles were dense, basophilic, round to ovoid granules (panel A, lymphocyte; panel B, neutrophil). Review of prior laboratory data reported abnormal granulation within lymphocytes and granulocytes for ∼14 months. Evaluation of the patient’s medication history revealed that she was started on chloroquine therapy ∼16 months prior. Follow-up identified no specific infectious etiology for the patient’s symptoms and the neutropenia resolved without intervention.
Morphologic changes have been described in leukocytes in patients undergoing chloroquine therapy. Changes seen may include an increase in cytoplasmic vacuoles, some containing irregular inclusions. One theoretical mechanism to explain this phenomenon includes an inhibitory effect of chloroquine on enzymes involved in degradation of lysosomal constituents. Such morphologic changes should be distinguished from intracellular organisms and signs of leukocyte activation (neutrophil toxic granulation, large granular lymphocytes). Careful review of clinical data and medication history may facilitate recognition of this phenomenon.
For additional images, visit the ASH IMAGE BANK, a reference and teaching tool that is continually updated with new atlas and case study images. For more information visit http://imagebank.hematology.org.